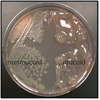

S1B5 - Neisseria Flashcards
(49 cards)
What is the most common cause of septic arthritis in sexually active people? What joint is often affected?
N. gonorrhoeae is the most common cause of septic arthritis in sexually active people, usually affecting the knee.

A 21-year-old college student presents complaining of a severe headache. He reports having had a fever and cough the night before. On physical examination, you note a stiff neck and photophobia. The patient is admitted and subsequently develops ecchymoses and bleeding from IV sites. Thrombocytopenia, low plasma fibrinogen, prolonged PT and aPTT are noted. Which is the most likely causative organism?
A) Enterovirus
B) Streptococcus pneumoniae
C) Herpes simplex virus type 2
D) Neisseria meningitidis
E) Haemophilus influenza type B
Neisseria meningitidis
Answer Explanation
All of the answer choices are potential causes of meningitis. Viruses are the most common cause. The development of disseminated intravascular coagulation (DIC) due to meningococcal sepsis. Meningococcus and Streptococcus pneumoniae are the most common bacterial causes of adult meningitis. S. pneumoniae meningitis from type B usually affects children under 5 who have not been vaccinated, so it is not the most likely in this case.

Untreated genital infection with Neisseria gonorrhoeae can progress to what condition in a female patient?
PID (pelvic inflammatory disease) results from untreated N. gonorrhoeae, which ascends the genital tract and infects the uterus, oviduct, and ovaries.

What are two treatment options for Neisseria meningitidis infection?
Treatment for N. meningitidis infection includes ceftriaxone or penicillin G.

Why are asplenics more susceptible to septicemia from Neisseria meningitidis infection?
The capsular polysaccharide acts as a barrier to phagocytosis or complement-mediated lysis. For this reason, asplenics are at an increased risk for septicemia.

What is the organism most often responsible for Waterhouse-Friderichsen syndrome?
Meningococcal meningitis and meningococcemia (from N. meningitidis) often result in shock and disseminated intravascular coagulation that can lead to adrenal infarction, a syndrome known as Waterhouse-Friderichsen syndrome.

How is Neisseria meningitidis transmitted? What occupations are often associated with Neisseria meningitidis infection?
N. meningitidis is carried in humans (5-10% are carriers) and normally colonizes the nasopharynx epithelium. Transmission occurs via respiratory droplets and often occurs in young adults living in close quarters such as military recruits and college students.

How is Neisseria meningitidis transmitted?
A) Fecal-oral route from an animal host
B) Exposure to body fluids during sexual intercourse
C) Inhalation of aerosolized bacteria from an animal host
D) Oral-fecal route from a human host
E) Inhalation of aerosolized bacteria from a human host
Inhalation of aerosolized bacteria from a human host
Answer Explanation
N. meningitidis is only found in humans, who can be asymptomatic carriers. It is transmitted via aerosol or nasopharyngeal secretions. N. gonorrhoeae is sexually transmitted.

What are two common infectious causes of ophthalmia neonatorum? How can these two infectious causes be differentiated?
Neonatal conjunctivitis (ophthalmia neonatorum) is typically caused by untreated N. gonorrhoeae or C. trachomatis in the maternal genitourinary tract, which is transmitted during vaginal delivery. N. gonorrhoeae-associated neonatal conjunctivitis usually occurs 1-5 days after birth, compared to 5-12 days in C. trachomatis-associated infection.

How is Neisseria gonorrhoeae transmitted?
N. gonorrhoeae is transmitted via direct contact in sexually active adults and teens, or during birth as the baby passes through the vaginal canal. N. gonorrhoeae can only survive within humans, and cannot be transmitted by fomites.

What diseases does Neisseria meningitidis cause?
N. meningitidis causes meningitis and meningococcemia with petechial rash.

What are the symptoms of Neisseria gonorrhoeae infection? How can this be differentiated from chlamydial infections?
Patients with urethritis and cervicitis from gonorrhea can present with pain or discomfort while urinating or pain during sexual intercourse, as well as a yellow/white thick mucopurulent discharge from the urethra or vagina. Contrast this with the clear/watery discharge seen in chlamydial infections.

What is the component of Neisseria meningitidis that is responsible for the septic shock and hemorrhage seen in Waterhouse-Friderichsen syndrome?
LOS is a component of the outer membrane of N. meningitidis. This acts as an endotoxin and is responsible for septic shock and hemorrhage, as seen in Waterhouse-Friderichsen syndrome.

What tests can be performed on the cerebrospinal fluid to detect a suspected N. meningitidis infection?
Diagnosis of N. meningitidis infection can be made via Gram stain showing diplococci within PMNs or latex agglutination test of the CSF for capsule.

Deficiency of what complement factors predisposes individuals to Neisseria infections?
Deficiency in the complement factors C5-C9, also known as the membrane attack complex (MAC), predisposes to Neisseria bacteremia.

What is the morphology, gram-staining, catalase-status, oxidase-status, glucose fermenting/non-fermenting of Neisseria?
Neisseria meningitidis and Neisseria gonorrhoeae are catalase-positive, oxidase-positive, glucose-fermenting, gram-negative diplococci.

What diseases (5) does Neisseria gonorrhoeae cause?
N. gonorrhoeae can cause
- Gonorrhea
- Septic arthritis
- Neonatal conjunctivitis
- Pelvic inflammatory disease (PID)
- Fitz-Hugh Curtis syndrome

How can N. meningitidis be identified from other Neisseria spp.?
In addition to fermenting glucose, N. meningitidis can also ferment maltose. This is in contrast to N. gonorrhoeae, which can only ferment glucose.

What is Fitz-Hugh Curtis syndrome?
Fitz-Hugh Curtis syndrome, or perihepatitis, consists of infection of the liver capsule and peritoneal surfaces of the anterior right upper quadrant. Acute symptoms manifest as a patchy purulent and fibrinous exudate known as “violin string” adhesions.

What is the clinical presentation of Neisseria meningitidis meningitis?
N. meningitidis-related meningitis presents with a sudden onset of
- Fever
- Nausea
- Vomiting
- Headache
- Mental status changes
- Myalgias
- Petechial rash (characteristic)

How is Neisseria gonorrhoeae infection diagnosed?
Diagnosis of N. gonorrhoeae is made primarily via nucleic acid amplification testing (NAAT).

What selective media can be used to culture Neisseria?
N. meningitidis and N. gonorrhoeae can both be cultured in a 5% CO2 atmosphere on Thayer-Martin agar (VPN), a selective medium for pathogenic Neisseria. Chocolate agar can be used if samples are taken from a sterile body fluid (blood or CSF).

What is the treatment regimen for Neisseria gonorrhoeae infection?
Treatment for N. gonorrhoeae infection includes ceftriaxone along with azithromycin or doxycycline for possible chlamydial infection.

What is the main virulence factor in Neisseria gonorrhoeae? What is its function?
The main virulence factor of N. gonorrhoeae is the pili (fimbriae), which allows attachment to mucosal surface and prevention of phagocytosis.